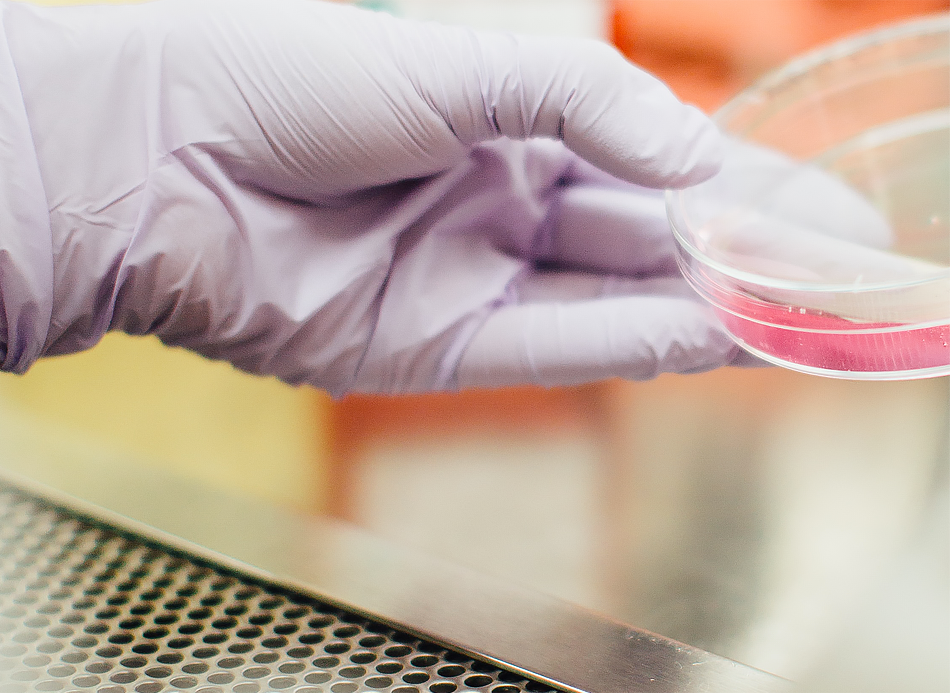

Commissariat
Aux Comptes
spécialisé en
Entreprises Innovantes
spécialisé en
Entreprises Innovantes
LCA Audit sécurise les entrepreneurs et les investisseurs grâce à son expertise des dispositifs en faveur de l'innovation (CIR, JEI, ...) et à sa connaissance intime des startups, de la biotechnologie au numérique.

Grâce au travail phénoménal de Lison Chouraki, les entrepreneurs, les investisseurs, et tous les acteurs de l’innovation en France, ont dans un seul livre pratique toutes les informations dont ils ont besoin sur le cadre légal, fiscal et financier de l’innovation en France, pour créer et développer une entreprise innovante, de l’idée jusqu’à l’introduction en Bourse.
Xavier Niel,
Fondateur et Vice-Président d'Iliad (Free)





Lison Dahan Chouraki est fondatrice et dirigeante de LCA Audit, commissaire aux comptes de plus de 40 startups dont des sociétés cotées sur le Nasdaq et sur Euronext Growth.
Elle est également l’auteur du Guide de la Jeune Entreprise Innovante, expert près la Cour d'Appel de Paris dans le domaine de l'évaluation d’entreprises et membre de la commission évaluation de la Compagnie Nationale des Commissaires aux Comptes. Elle a été administrateur et trésorière de l'association France Biotech de 2004 à 2014.
Lison Dahan Chouraki est fondatrice et dirigeante de LCA Audit, commissaire aux comptes de plus de 40 startups dont des sociétés cotées sur le Nasdaq et sur Euronext Growth.
Elle est également l’auteur du Guide de la Jeune Entreprise Innovante, expert près la Cour d'Appel de Paris dans le domaine de l'évaluation d’entreprises et membre de la commission évaluation de la Compagnie Nationale des Commissaires aux Comptes. Elle a été administrateur et trésorière de l'association France Biotech de 2004 à 2014.
Une équipe de proximité, disponible et impliquée, disposant d’une solide expertise de l’audit des sociétés healthcare, et évoluant dans un environnement de travail anglo-saxon.